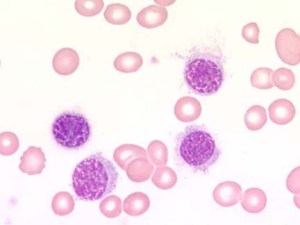

On 3rd March of this year I was diagnosed with a chronic lymphoid leukemia with the scary name of Hairy Cell Leukemia. I’ve just finished my chemotherapy treatment – and beginning to feel now like I’m coming out the other side.
People familiar with me on Twitter would have known back last summer that on a camping weekend in Lough Key – I successfully managed to badly hurt my knee in the Boda Borg adventure playground.
I did the man-flu/stoic act over the next few months – thinking that it would get better – when very obviously simple things like walking without having any pain – were becoming a distraction.
So in early october, I decided that I would get value for money from my next GP visit; Get a referral letter for a knee x-ray/MRI and at the same time get all my bloods checked.
All fine so far – the X-ray was arranged – but my White Blood Cell count (WBC) were coming back in the low range. At this point I was referred to Haematology Out-Patients in Sligo General – and thus started the monthly visits for out-patient blood tests which each time added progressive tests for the various infections that might be causing the low counts.
Now during all of this – I was feeling fine. My energy levels weren’t what they used to be – but I had in my own mind related this with my inability to go for my walks in the evening rather than with anything else. At the same time though, the natural human instinct is to worry and to gloomily postulate and I did some of the this – strangely much of it in the dreaming state.
With my early December results – it was quite clear though that something was amiss. My Absolute Neutrophil count – the type of white blood that fights infection – was down to 0.57; the normal range for this is 2.0 – 7.5; I was asked to avoid crowds, people with colds, flus and and so on.
The next step was to have a bone marrow aspirate – this is the point where you know your medical people really want to get down to business. A small core of bone marrow is taken from the hip and examined for well – the things that it is examined for. The initial result from this test came back clear – I was informed that the low counts were due to a viral infection – but this was clarified with further investigation on March 3rd with a diagnosis of Hairy Cell Leukemia.
This refinement of the diagnosis from “viral infection” to something a tad more more serious did not really bother me too much – all along I just knew that the former just seemed to straight forward, too simple.
There was a vague element of satisfaction in knowing that my gut feeling had been vindicated. I’m not so sure if this is considered a normal reaction to such news – all I know is that it was normal for me.
Given the nature of Hairy Cell Leukemia – a chronic but incurable disease – I was also given the option of postponing treatment for a number of years until the symyptoms were more manifest. Postponement did not really appeal to me though – I chose to go ahead with treatment as quickly as possible.
So the last few months have been pretty busy. At the beginning of March I received my official HCL diagnosis; I then had my knee arthroscopy completed, with my chemotherapy treatment starting in early April.
Chemotherapy has consisted of 6 weekly treatments (about 2 hours of infusion) of Cladribine. This protocol originated out of St James’s Hospital in Dublin – the treatment regime that is most common is having infusion over 5 or 7 days continuously.
Yes – I have had some side effects – but not the ones you expect with “normal” chemo treatments – for example hair loss and nausea. There have been headaches, fatigue, pains – and I have spent just 10 days or so in hospital with fever – the risk of infection while having this treatment is high, as overall white blood counts can go very low – before they start to slowly recover.
In my case my overall WBC was down to .54 with my Neutrophils hovering at practically zero for about a week or so while I was in hospital.
I’ve also had a chemo related rash – for the last few weeks or so. This is pretty irritating (very itchy) – it initially started off chicken pox like, then mellowed to something resembling all-over sunburn, peeled – and then I started to get it a second time. Weird side-effects of steroids that I was prescribed included fluid retention (swollen ankles) and a weak sounding voice that you would associate with larnygitis.
On the whole though – I cannot really complain and consider myself lucky. HCL is a pretty indolent disease and my chances of recovery are over 95%. However I will probably need further treatment in the years to come – this could be two, five or ten or more years from now.
In the past few months – I’ve seen a lot of people who are much sicker than I, whose prognosis in reality is not that favourable. My odds are not that bad. As my doctor often says – the odds are more likely for me to be knocked down by a bus.
With regard to HCL itself – by all accounts it’s a pretty rare disease. Working on statistics from the US and the Irish Cancer registry – I reckon there are probably less than 10 cases in Ireland per year.
From that point of view – unlike more mainstream online resources – this has made it more difficult to research and interact with other patients. The best I have found so far for Hairy Cell Leukemia patients
is the User Friendly HCL Forum – a pretty excellent, niche forum for all things HCL.
All the while during treatment and since – I have been continuing to work, but at a slower rate. With my confidence and strength returning – my output is beginning to improve, and it feels great to be back at work. While I have had to turn down work during over the past few months – I have started to make some appointments for later this month – so I just know things are starting to improve.
In wrapup – this is not a sympathy post – it’s just a matter of fact, as much as it can be – of where I’ve been over the past few months. I’m very much looking forward to the summer, to work, to life and most of all to my family.
Jeepers Kevin, sorry to hear that. I saw your tweet saying you were out for a week but thought you’d had a migraine. Good to see the prognosis is good, if you need a hand at anything at all do give me a shout.
I hadnt read this when i was talking to you earlier – Speedy recovery Kevin…
Kevin,
Inspiring post. I had my own ‘bit of bother’ as one would say down west just three years ago so can identify with some of the inner moments.
You calmness is inspiring and emphasises the value of living for what one has rather than than what one hasn’t.
Padraig
Hi Kevin
I’m so sorry to hear about your diagnosis, but thanks for sharing with such a great blog post. I found myself in a similar situation last year- I was diagnosed with APML which is another rare type of Leukemia, but with a slightly different treatment protocol. It can be a scary time, but as you’ve pointed to one of the frustrating parts can be trying to find personal accounts online, especially irish ones. It’s wonderful that you’ve posted about it, it’ll make it that bit easier for someone else with a diagnosis who comes along.
I’m on the other-side of chemo now, but still receiving a low dose as part of a maintenance programme, but I have to say things are going great, even if the energy isn’t back 100% just yet! I hope you’re doing well and have no doubt you’ll be back at full tilt in no time. I’m sure you realise even more now how many great friends and family you have, and I hope you have a fantastic summer enjoying them all.
I know it’s a different kind but my blog post about my diagnosis is here in case it helps to hear about others in a similar situation. http://stranded.ie/2010/09/24/the-l-word
Thanks Eddie, Mary & Padraig for your kind words – hope to catch up with you all in the near future at whatever the occasion might be!
Aoife – it was actually your blog post that galvanised me to put some words together myself – so thanks for that.
Our approach is not for everyone – that is very obvious. One of my main motivations was probably like yourself – comfortable enough in my own skin to be honest, giving everyone a heads up as well as ensuring that there is information for others that come after us.
Developed,h.c.l,in95.at42,am,now.60,had,same.treatment.in,James.hospital.love,around.corner.from.hospital.i,use,pesticidesin95,in.my.work,just,go.once.ayear.for.check.up,had.same,side.affects.sunburn.fatigue.sometimes,food.sticks.inyour,stomach,for.ages